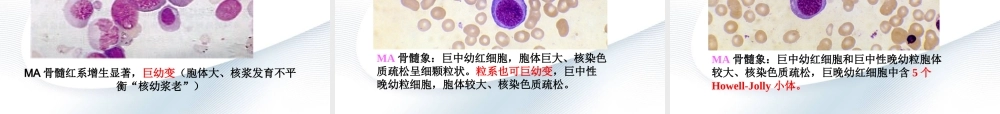
巨幼细胞性贫血.ppt

巨幼细胞性贫血(megaloblasticanemia,MA)黔西南州人民医院血液内科---付星概述定义病因发病机制临床表现实验室检查鉴别诊断治疗定义巨幼细胞性贫血(megaloblasticanemia)是脱氧核糖核酸(DNA)合成的生物化学障碍及DNA复制速度减缓所致的疾病。通常是缺乏叶酸、维生素B12所引起的营养性大细胞贫血。•1.摄入不足•2.需要量增加•3.吸收不良:胃肠道疾病、药物干扰和内因子抗体形成(恶性贫血)•4.代谢异常:肝病、某些抗肿瘤药物的影响•5.利用障碍:嘌呤、嘧啶自身合成异常或化疗药物影响等。营养性巨幼红细胞性贫血发病机制发病机制VitB12↓叶酸↓VitB12↓叶酸↓RBCRBC核发育落后于细胞浆核发育落后于细胞浆RBC体积变大RBC体积变大巨幼红细胞巨幼红细胞叶酸四氢叶酸VitB12催化四氢叶酸↓四氢叶酸↓DNA合成↓DNA合成↓RBC分裂、增殖时间↑Hb合成不受影响RBC分裂、增殖时间↑Hb合成不受影响25/1/20营养性巨幼红细胞性贫血长(long)呆(dull)呆(dull)巨(huge)巨(huge)25/1/20营养性巨幼红细胞性贫血长长2/3为6~12月,2岁后少见。。病程长,起病缓慢长期母乳喂养蔬菜烹煮时间过长25/1/20营养性巨幼红细胞性贫血呆一般表现•虚胖•毛发稀疏•发黄•轻至中度贫血精神神经症状•呆滞、反应迟钝•不呆痴呆•震颤•血液系统:肝、脾、淋巴结肿大。•消化系统:厌食、腹泻等。25/1/20营养性巨幼红细胞性贫血巨(实验室检查)血象呈大细胞性贫血红细胞大小不等、出现巨大的红细胞正常红细胞巨红细胞巨红细胞巨红细胞巨红细胞实验室检查血象:中性粒细胞变大,有分叶过多现象。骨髓:原红、早幼红相对多,各期幼红细胞巨幼变(巨)生化实验:血清VitB12<100ng/ml(74pmol/L)VitB12缺乏血清叶酸<6.8nmol/L(3ng/ml)叶酸缺乏红细胞叶酸<227nmol/L(100ng/ml)25/1/20营养性巨幼红细胞性贫血正常外周血RBC形态正常外周血RBC形态正常红细胞大小较为一致,直径6~9um在各种贫血时,红细胞可出现大、小不一。直径>10um为大红细胞,>15um为巨红细胞。正常杆状核或分叶核粒细胞直径为1015um正常红细胞大小较为一致,直径6~9um在各种贫血时,红细胞可出现大、小不一。直径>10um为大红细胞,>15um为巨红细胞。正常杆状核或分叶核粒细胞直径为1015um25/1/20营养性巨幼红细胞性贫血MA血象:红细胞大小不均,易见大红细胞、巨红细胞、椭圆形红细胞。一个分叶过多的中性粒细胞。可见高色素性大红细胞、中心淡染区消失。MA血象:双核巨晚幼红细胞、含一个Howell-J...